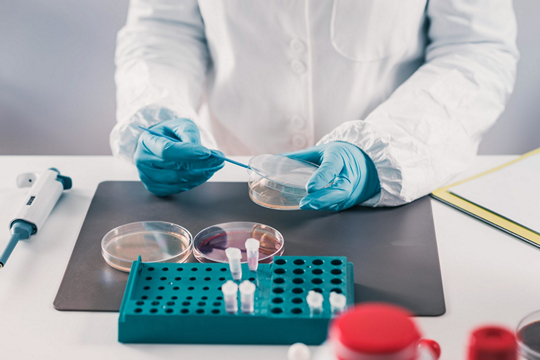
Гиповитаминоз

Туйчиева Камила Шавкатовна
Врач-терапевт, врач-диетолог, врач превентивной интегративной медицины , Врач – диетолог, врач – терапевт
Гиповитаминозы (авитаминозы) – это болезни и недуги, возникающие из-за недостатка витаминов. Из-за дефицитных состояний возникают нарушения обмена веществ с типичными для них симптомами. Дискомфорт, возникающий в результате гиповитаминозов, обычно полностью отступает при грамотном лечении.

Клиническая картина зависит от того, дефицит какого витамина возник:
Остеомаляция представляет собой дефицит кальциферола (витамина D) и приводит к размягчению или хрупкости костей у взрослых. Также следует выделить такой симптом гиповитаминоза, как цинга вызвана недостатком аскорбиновой кислоты (витамина С) и влечет за собой язвенное заболевание слизистой оболочки полости рта с кровоточивостью десен, а также кровоизлияния в кожу и мышцы.
Недоедание – это тот случай, когда нормальная пища подается или усваивается организмом в недостаточном количестве. Это, помимо нехватки энергии, обычно приводит к гиповитаминозам. В качестве причины также следует рассматривать одностороннюю диету.
Абсорбция – это способность организмов поглощать (усваивать) вещество. При соответствующем расстройстве всасывания организм больше не может неадекватно поглощать вещество. Примерами нарушений рассасывания являются:
Рахит (дефицит витамина D) развивается преимущественно у младенцев и маленьких детей, при несбалансированном питании и/или недостатке солнечного света.
Физический стресс также может быть триггером гиповитаминоза, примерами этого являются перенесенные инфекционные заболевания, травмы, операции, а также хронические заболевания, которые ослабляют организм. Кроме того, Использование лекарств может повлиять на функцию органов обработки витаминов. Психологические стрессы также могут вызывать расстройства пищевого поведения и, таким образом, привести к дефициту.
Такие заболевания, как нарушения функций печени, почек и диабет, также вызывают гиповитаминозы. Дефицит витамина D может возникать при различных формах аллергии на свет, т. к. заболевшие люди часто не могут находиться в солнечном свете достаточно долго, чтобы стимулировать кожу к образованию витамина D.
Физикальное обследование выявит многие из ранних симптомов авитаминоза, таких как усталость, раздражение, тошнота, запор и плохая память, но дефицит может быть трудно определить. Также необходима информация о рационе человека и общем состоянии его здоровья. Диагностика гиповитаминоза включает:
Лечение витаминами группы В устраняет дефицитные состояния и снимает большинство симптомов. Тяжелая недостаточность лечится высокими дозами, вводимыми внутримышечно или внутривенно в течение нескольких дней. Затем меньшие дозы можно вводить путем инъекций или в виде таблеток, пока пациент не выздоровеет.
Дополнительные меры при лечении гиповитаминоза:
Авитаминоз смертелен, если его не лечить. Чем дольше существует дефицит, тем больше осложнений развивается. Большинство симптомов можно обратить вспять, и полное выздоровление возможно, когда уровень витаминов возвращается к норме и поддерживается сбалансированной диетой и витаминными добавками по мере необходимости.
Сбалансированная диета, содержащая все необходимые питательные вещества, предотвратит гиповитаминоз. Люди, которые потребляют большое количество нездоровой пищи, такой как чипсы, конфеты и продукты с высоким содержанием углеводов, приготовленные из необогащенной муки, могут испытывать дефицит жизненно важных питательных веществ. Они могут нуждаться в витаминных добавках и должны улучшить свой рацион.
В клинике «Хадасса» в Москве работают иностранные врачи по международным протоколам. При необходимости используются незарегистрированные в России лекарственные препараты.
Рулева А. А. Весенний гиповитаминоз у детей //Вопросы современной педиатрии. – 2011. – Т. 10. – №. 2. – С. 155-161.
Муханова К. А., Сундюкова Е. В., Коршунова И. Н. ГИПОВИТАМИНОЗ КАК ФАКТОР РИСКА ПОВЫШЕНИЯ ЗАБОЛЕВАЕМОСТИ И СНИЖЕНИЯ РАБОТОСПОСОБНОСТИ В МОЛОДОМ ВОЗРАСТЕ //Валеопедагогические проблемы здоровьеформирования. – С. 65.
Литвицкий П. Ф. Нарушения обмена витаминов //Вопросы современной педиатрии. – 2014. – Т. 13. – №. 4. – С. 40-47.
Рахимова Д., Аскарова Н. Гиповитаминозы у военнослужащих //Общество и инновации. – 2021. – Т. 2. – №. 3/S. – С. 90-99.
Руденко Е. В. Гиповитаминоз D у взрослых-факторы риска, диагностика, профилактика, лечение //Медицинские новости. – 2021. – №. 7 (322). – С. 37-41.
Прием (осмотр, консультация) врача-диетолога первичный
B01.013.001
10 000 ₽
Прием (осмотр, консультация) врача-диетолога повторный
B01.013.002
8 500 ₽
Удаленная консультация врача-диетолога
B01.013.001.021
8 500 ₽
Удаленная консультация врача-диетолога, кандидата медицинских наук
B01.013.001.022
11 000 ₽
Удаленная консультация ведущего врача-диетолога
B01.013.001.042
11 000 ₽
Удаленная консультация врача-диетолога, руководителя Центра компетенций диетологии Института гастроэнтерологии и гепатологии
B01.013.001.023
14 000 ₽
Удаленная консультация)врача-диетолога, руководителя Центра компетенций диетологии Института гастроэнтерологии и гепатологии, с составлением индивидуального рациона питания на 7 дней
B01.013.001.024
25 000 ₽
Составление меню диетического питания
A23.30.051
17 800 ₽
Прием (осмотр, консультация) врача-диетолога, кандидата медицинских наук, первичный
B01.013.001.002
13 000 ₽
Прием (осмотр, консультация) врача-диетолога, кандидата медицинских наук, повторный
B01.013.002.002
11 000 ₽
Прием (осмотр, консультация) ведущего врача-диетолога первичный
B01.013.001.011
13 000 ₽
Прием (осмотр, консультация) ведущего врача-диетолога повторный
B01.013.002.011
11 000 ₽
Прием (осмотр, консультация) врача-диетолога, руководителя Центра компетенций диетологии Института гастроэнтерологии и гепатологии, первичный
B01.013.001.050
16 000 ₽
Прием (осмотр, консультация) врача-диетолога, руководителя Центра компетенций диетологии Института гастроэнтерологии и гепатологии, повторный
B01.013.002.050
14 000 ₽
Прием (осмотр, консультация)врача-диетолога, руководителя Центра компетенций диетологии Института гастроэнтерологии и гепатологии, с составлением индивидуального рациона питания на 7 дней, первичный
B01.013.001.051
21 000 ₽
Прием (осмотр, консультация)врача-диетолога, руководителя Центра компетенций диетологии Института гастроэнтерологии и гепатологии, с коррекцией индивидуального рациона питания на 7 дней, повторный
B01.013.002.051
18 000 ₽